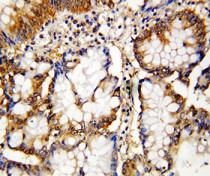

ARG58013
anti-Caspase 10 antibody
anti-Caspase 10 antibody for IHC-Formalin-fixed paraffin-embedded sections,Western blot and Human
概述
| 产品描述 | Rabbit Polyclonal antibody recognizes Caspase 10 |
|---|---|
| 反应物种 | Hu |
| 应用 | IHC-P, WB |
| 宿主 | Rabbit |
| 克隆 | Polyclonal |
| 同位型 | IgG |
| 靶点名称 | Caspase 10 |
| 抗原物种 | Human |
| 抗原 | Synthetic peptide corresponding to aa. 220-236 of Human Caspase 10 (large subunit). (VKTFLEALPRAAVYRMN) |
| 偶联标记 | Un-conjugated |
| 別名 | Caspase-10; EC 3.4.22.63; ICE-like apoptotic protease 4; Apoptotic protease Mch-4; FAS-associated death domain protein interleukin-1B-converting enzyme 2; FLICE2; CASP-10; ALPS2; MCH4 |
应用说明
| 应用建议 |
|
||||||
|---|---|---|---|---|---|---|---|
| 应用说明 | * The dilutions indicate recommended starting dilutions and the optimal dilutions or concentrations should be determined by the scientist. |
属性
| 形式 | Liquid |
|---|---|
| 纯化 | Affinity purification with immunogen. |
| 缓冲液 | PBS, 0.025% Sodium azide and 2.5% BSA. |
| 抗菌剂 | 0.025% Sodium azide |
| 稳定剂 | 2.5% BSA |
| 浓度 | 0.5 mg/ml |
| 存放说明 | For continuous use, store undiluted antibody at 2-8°C for up to a week. For long-term storage, aliquot and store at -20°C or below. Storage in frost free freezers is not recommended. Avoid repeated freeze/thaw cycles. Suggest spin the vial prior to opening. The antibody solution should be gently mixed before use. |
| 注意事项 | For laboratory research only, not for drug, diagnostic or other use. |
生物信息
| 数据库连接 | |
|---|---|
| 基因名称 | CASP10 |
| 全名 | caspase 10, apoptosis-related cysteine peptidase |
| 背景介绍 | This gene encodes a protein which is a member of the cysteine-aspartic acid protease (caspase) family. Sequential activation of caspases plays a central role in the execution-phase of cell apoptosis. Caspases exist as inactive proenzymes which undergo proteolytic processing at conserved aspartic residues to produce two subunits, large and small, that dimerize to form the active enzyme. This protein cleaves and activates caspases 3 and 7, and the protein itself is processed by caspase 8. Mutations in this gene are associated with type IIA autoimmune lymphoproliferative syndrome, non-Hodgkin lymphoma and gastric cancer. Alternatively spliced transcript variants encoding different isoforms have been described for this gene. [provided by RefSeq, Apr 2011] |
| 生物功能 | Involved in the activation cascade of caspases responsible for apoptosis execution. Recruited to both Fas- and TNFR-1 receptors in a FADD dependent manner. May participate in the granzyme B apoptotic pathways. Cleaves and activates caspase-3, -4, -6, -7, -8, and -9. Hydrolyzes the small- molecule substrates, Tyr-Val-Ala-Asp-|-AMC and Asp-Glu-Val-Asp-|-AMC. Isoform C is proteolytically inactive. [UniProt] |
| 预测分子量 | 59 kDa |
| 翻译后修饰 | Cleavage by granzyme B and autocatalytic activity generate the two active subunits. [UniProt] |
检测图片 (2) Click the Picture to Zoom In
-
ARG58013 anti-Caspase 10 antibody IHC-P image
Immunohistochemistry: Paraffin-embedded Human intestinal cancer tissue stained with ARG58013 anti-Caspase 10 antibody.
-
ARG58013 anti-Caspase 10 antibody WB image
Western blot: 1) COLO320, 2) HeLa, 3) SW620 and 4) Raji cell lysates stained with ARG58013 anti-Caspase 10 antibody.